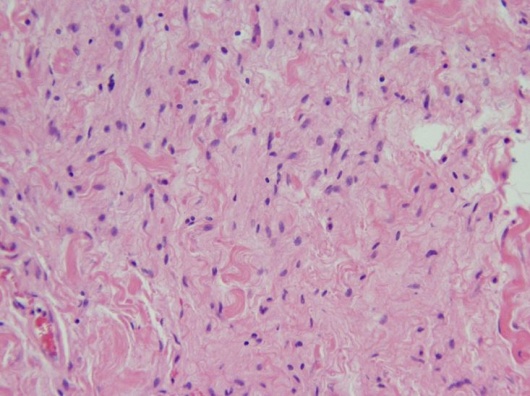
Orbital Neurofibroma - H&E.JPG

Orbital Neurofibroma
All content on Eyewiki is protected by copyright law and the Terms of Service. This content may not be reproduced, copied, or put into any artificial intelligence program, including large language and generative AI models, without permission from the Academy.
Orbital neurofibromas are peripheral nerve sheath neoplasms derived from Schwann cells, perineural cells and fibroblasts.[1] They can manifest within the orbit, and they may or may not be associated with systemic neurofibromatosis.
Disease Entity
Incidence
Neurofibromas, relatively uncommon orbital lesions, represent approximately 2-4% of orbital tumors. Plexiform neurofibromas account for 2%, and localized neurofibromas account for 1%.[2] [3]
Classification
Neurofibromas may broadly be classified as plexiform, diffuse, or localized tumors.
Plexiform Neurofibromas
Plexiform neurofibromas are the most common subtype encountered in the orbit and are closely associated with Neurofibromatosis type 1 (NF1). Some authors consider these tumors to be pathognomonic for NF1, though case reports of orbital plexiform neurofibomas in the absence of other findings suggest that these lesions may instead be highly suggestive of the diagnosis.[4] [5] They typically present early in life and appear clinically as infiltrative, multinodular masses growing along the course of peripheral nerves. Like diffuse neurofibromas, they are typically poorly circumscribed and vascular.[1] Classic characteristics include a “bag-of-worms” consistency and eyelid involvement producing an S-shaped deformity. Approximately 20% of tumors associated with NF1 may undergo malignant transformation.[2]
Diffuse Neurofibromas
A more recently recognized variant similar to plexiform neurofibroma, diffuse (or diffuse plexiform) neurofibroma is vascular, infiltrative in nature, and presents early in life. Diffuse neurofibromas demonstrate infiltration into the subcutaneous fat leading to a distinct clinical appearance of dermal and subcutaneous thickening. They are thought to be congenital, though they may not be apparent at birth. Diffuse neurofibromas are associated with NF1 in at least 10% of cases.[6] [7]
Localized Neurofibromas
Localized (or isolated) neurofibromas are focal, well-circumscribed neoplasms that typically present in the superior orbit during the third to fifth decade of life with a slowly progressive mass effect.[4] They most frequently involve branches of the frontal nerve.[3] 11-28% of patients with localized neurofibromas have a family history or systemic signs of NF1.[1] In the absence of NF1, they only rarely undergo malignant degeneration.[8] These tumors are less vascular than plexiform and diffuse neurofibromas, and they can often be differentiated from plexiform and diffuse lesions by imaging studies. The occurrence of multiple localized neurofibromas has been reported and may represent a “form fruste” NF1.[4]
Neurofibroma versus Schwannoma
Neurofibromas can be distinguished from schwannomas, other peripheral nerve sheath tumors, in several ways. In contrast to schwannomas, neurofibromas are soft, unencapsulated and involve a number of other cell types in addition to Schwann cells.[4][9] Schwannomas do not invade the neural tissue and their growth compresses the adjacent nerve, whereas neurofibromas invade and enlarge the nerves from which they are derived. Neurofibromas can also be distinguished on histopathological examination by multiple different characteristics, including the presence of nerve fibers within the tumor.[10]
Etiology
Neurofibromas are peripheral nerve sheath neoplasms derived from a combination of Schwann cells, axons, perineural cells and fibroblasts interspersed with collagen and a myxoid matrix [9], sometimes in association with NF1. The NF1 gene is a tumor suppressor whose gene product, neurofibromin, is a down regulator of the proto-oncogene p21-ras.[11]
Systemic Associations
Plexiform neurofibromas are almost always associated with NF1, whereas localized neurofibromas are associated with NF1 in a minority of cases. NF1 is a neurocutaneous disorder that affects 1 in 3000 individuals and is characterized by multiple café au lait spots and cutaneous neurofibromas. It is inherited in an autosomal dominant fashion, although 50% of cases may be sporadic, and has been mapped to a gene locus on chromosome 17q11.2.[11]
According to the NIH diagnostic criteria, the diagnosis of NF1 is made with the presence of two of the following:
- Six or more café au lait macules >5 mm in diameter in prepubertal individuals, and >15mm in diameter in postpubertal individuals
- Two or more neurofibromas of any type, or one plexiform neurofibroma
- Freckling in the axillary or inguinal regions
- Optic nerve glioma
- Two or more Lisch nodules (iris hamartomas)
- A distinctive bony lesion such as sphenoid dysplasia or thinning of the long bone cortex with or without pseudoarthrosis
- A first degree relative (parent, sibling, or offspring) with NF1 by the above criteria
Several other systemic associations exist with NF1, including an increased frequency of CNS tumors, cognitive deficits, seizures, cerebrovascular dysplasia, and hypertension. Life expectancy appears to be modestly shortened in patients with NF1, though data are limited.[11]
Genetic testing is available for NF1 mutations, but results do not necessarily indicate the severity or potential manifestations of the disease for an individual patient.[11]
General Pathology
Localized Neurofibromas
Histopathologic evaluation of localized neurofibromas demonstrates a pseudocapsule surrounding loosely arranged bundles of perineural cells, fibroblasts, and Schwann cells, which may be in complexes with axons.[1][12] Nuclei may be fusiform, elongated, or comma-shaped.[9][12]Variable amounts of collagen deposition and myxoid stroma are also present, and immunohistochemical studies show a positive reaction to S-100.[1][12]
Localized Orbital Neurofibroma (H&E, 20x). Wavy tumor cells with comma-shaped nuclei forming loose bundles in myxoid stroma.
Localized Orbital Neurofibroma (S-100 immunoperoxidase stain, 20x). Positive S-100 staining.
Plexiform Neurofibromas
Plexiform neurofibromas consist of tortuous bundles of hypertrophic, disorganized nerves and perineural components. Axons are seen in association with Schwann cells and fibroblasts, and the lesions may lack clear margination. Plexiform neurofibromas often show increased myxoid extracellular material.[4] As with isolated neurofibromas, these lesions show a positive reaction to S-100 on immunohistochemistry.[2]
Malignant Neurofibromas
Malignant neurofibromas may be characterized by increased cellularity, pleomorphism, and mitotic figures.[9]
Diagnosis
Clinical Features
Orbital neurofibromas typically present with progressive symptoms of an orbital mass, including proptosis, globe displacement, impaired extraocular motility, ptosis, sensory dysfunction (numbness) and, uncommonly, optic neuropathy with decreased visual acuity.[1][9] Plexiform neurofibromas often manifest during the first decade of life, whereas localized neurofibromas present in the third to fifth decade.
34 year old male with ptosis, hypoglobus, and proptosis of the right eye secondary to a localized neurofibroma of the right, superior orbit.
Other manifestations of NF1 may be present, including Lisch nodules and optic pathway gliomas which may be found on ophthalmic examination:
- Lisch nodules are iris hamartomas that increase in frequency with age, being uncommon in young children but present in over 90% of adults with NF1.[11]
- Optic pathway gliomas (OPGs) are low grade neoplasms (most often pilocytic astrocytomas) that may occur sporadically, but typically affect children under the age of 6 with NF1.[13] Regular ophthalmologic screening is recommended for patients with NF1, and 20% will develop an optic pathway glioma.[14] They can affect the optic nerve, chiasm, tract, or radiation. They were previously thought to be benign but are now known to demonstrate variable growth that is difficult to predict. OPGs often present with decreased acuity. They can be diagnosed on MRI which classically demonstrates fusiform enlargement of the optic nerve with a downward kink in the orbit. Management is controversial, though often involves periodic MRI evaluation with consideration of treatment for progression, severe visual impairment or poor prognostic factors. Given the risks of surgery and radiation, initial treatment most commonly consists of a chemotherapeutic regimen such as carboplatin and vincristine.[13]
- Glaucoma and choroidal hamartomas may also be seen in patients with NF1.[14]
Diagnostic Imaging
Imaging of localized neurofibromas shows smoothly marginated ovoid lesions[1][12] which may or may not be lobulated. On CT, they appear isodense or hypodense to extraocular muscles and show variable contrast enhancement with some reports of ring-enhancing characteristics.[1][10] MRI demonstrates low-moderate T1 signal intensity and moderate-high T2 signal intensity. There may be heterogeneity of signal strength within the lesion, reflecting the mixed histopathology and vascularity of the tumors.[1][12] As with CT, contrast enhancement is variable on MRI.
T1 MRI image showing a 24x12x16 millimeter right, superior orbital neurofibroma that appears as an isointense, well circumscribed, extraconal mass.
Imaging of plexiform neurofibromas demonstrates multi-lobulated, non-encapsulated tumors that lack clear margination[1][15] and cause diffuse thickening of the involved nerve. As with localized neurofibromas, they tend to show low attenuation on CT, isointensity on T1, and hyperintensity on T2 weighted images[15] with variable contrast enhancement.
Management
Treatment decisions for localized neurofibromas depend on the severity of clinical signs and symptoms. If indicated, surgical removal is facilitated by the relatively low vascularity, pseudocapsule, and circumscribed nature of the lesion. Excision is achieved through an anterior or lateral orbitotomy, depending on the location and size of the lesion, and is typically curative.[1][4]
The periorbital deformities of orbitotemporal neurofibromatosis include upper eyelid infiltration with ptosis, lateral canthal disinsertion and infiltration of lower eyelid, brow, conjunctiva and lacrimal gland. The appearance of patients with orbitotemporal neurofibromatosis can be significantly improved through oculoplastic surgery. [16]
Plexiform neurofibromas are more difficult to remove because of their relative vascularity and lack of clear margination. Removal may be complicated by subtotal resection, and recurrence or re-growth is common.[3] Large lesions may ultimately require exenteration.[2]
Prognosis
Neurofibromas in the setting of NF1 develop malignant transformation in 20% of cases[2] and require routine monitoring.
In the absence of NF1, localized neurofibromas rarely undergo malignant transformation, but recurrence has been occasionally reported following surgical removal.[1] Patients should be advised to have routine follow up with their EyeMD ophthalmologist.
References
- ↑ 1.00 1.01 1.02 1.03 1.04 1.05 1.06 1.07 1.08 1.09 1.10 1.11 Lee LR, Gigantelli JW, Kincaid MC.Localized neurofibroma of the orbit: a radiographic and histopathologic study.Ophthal Plast Reconstr Surg. 2000 May;16(3):241-6.
- ↑ 2.0 2.1 2.2 2.3 2.4 Karcioglu Z. Clinicopathologic Correlates in Orbital Disease. Duane’s Foundations of Clinical Ophthalmology, Volume 3, Chapter 17. Lippincott Williams & Wilkins, 2006 edition on CD-ROM.
- ↑ 3.0 3.1 3.2 Misra S, et al. Recurrent neurofibroma of the orbit. Australas Med J. 2013 Apr 30;6(4):189-91.
- ↑ 4.0 4.1 4.2 4.3 4.4 4.5 Cannon T, Carter K, Folberg R. Neurogenic Tumors of the Orbit. Duane’s Clinical Ophthalmology, Volume 2, Chapter 41. Lippincott Williams & Wilkins, 2006 edition on CD-ROM.
- ↑ Bechtold D, et al. Plexiform neurofibroma of the eye region occurring in patients without neurofibromatosis type 1. Ophthal Plast Reconstr Surg. 2012 Nov-Dec;28(6):413-5.
- ↑ Van Zuuren EJ, Posma AN. Diffuse neurofibroma on the lower back. J Am Acad Dermatol. 2003 Jun;48(6):938-40.
- ↑ Kumar BS. Diffuse neurofibroma of the scalp presenting as circumscribed alopecic patch. Int J Trichology. 2010 Jan;2(1):60-2.
- ↑ Cheng SF. Malignant peripheral nerve sheath tumor of the orbit: malignant transformation from neurofibroma without neurofibromatosis. Ophthal Plast Reconstr Surg. 2008 Sep-Oct;24(5):413-5.
- ↑ 9.0 9.1 9.2 9.3 9.4 Chesnutt D. Tumors of Cranial and Peripheral Nerves. Walsh and Hoyt’s Clinical Neuro-Ophthalmology 6th Edition, Section 7, Chapter 33. Lippincott Williams & Wilkins, 2005.
- ↑ 10.0 10.1 http://www.uptodate.com/contents/peripheral-nerve-tumors?source=preview&anchor=H30353371&selectedTitle=3~44#H30353371 (Accessed 6/10/2013)
- ↑ 11.0 11.1 11.2 11.3 11.4 http://www.uptodate.com/contents/neurofibromatosis-type-1-von-recklinghausens-disease?source=search_result&search=neurofibroma&selectedTitle=2~44 (Accessed 6/10/2013)
- ↑ 12.0 12.1 12.2 12.3 12.4 Kottler UB, et al. Isolated neurofibroma of the orbit with extensive myxoid changes: a clinicopathologic study including MRI and electron microscopic findings. Orbit. 2004 Mar;23(1):59-64.
- ↑ 13.0 13.1 Avery RA, Fisher MJ, Liu GT. Optic pathway gliomas. J Neuroophthalmol. 2011 Sep;31(3):269-78.
- ↑ 14.0 14.1 Gaonker CH, Mukherjee AK, Pokle M. Involvement of the eye and orbit in neurofibromatosis type 1. Indian J Ophthalmol. 1992 Jan-Mar;40(1):2-4.
- ↑ 15.0 15.1 Santaolalla F, et al. Severe exophthalmos in trigeminal plexiform neurofibroma involving the orbit and the infratemporal fossa. J Clin Neurosci. 2009 Jul;16(7):970-2.
- ↑ Cui Y, Li Y, Hou ZJ, Ding JW, Li DM, Clinical features and surgical management of orbitotemporal neurofibromatosis, .Zhonghua Yan Ke Za Zhi. 2019 Nov 11;55(11):828-833. doi:10.3760/cma.j.issn.0412-4081.2019.11.008.